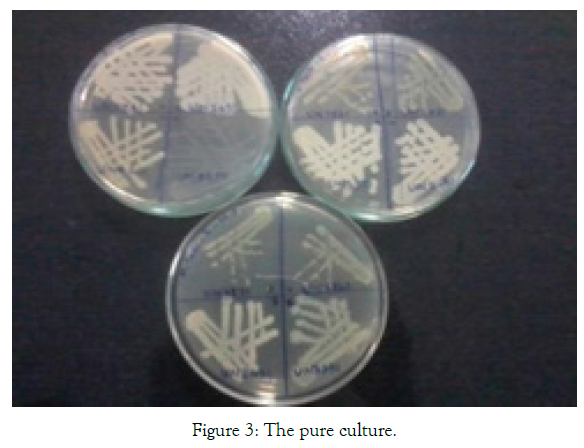

Indexed In
- Open J Gate
- Genamics JournalSeek
- ResearchBible
- Electronic Journals Library
- RefSeek
- Hamdard University
- EBSCO A-Z
- OCLC- WorldCat
- SWB online catalog
- Virtual Library of Biology (vifabio)
- Publons
- Euro Pub
- Google Scholar
Useful Links
Share This Page
Journal Flyer

Open Access Journals
- Agri and Aquaculture
- Biochemistry
- Bioinformatics & Systems Biology
- Business & Management
- Chemistry
- Clinical Sciences
- Engineering
- Food & Nutrition
- General Science
- Genetics & Molecular Biology
- Immunology & Microbiology
- Medical Sciences
- Neuroscience & Psychology
- Nursing & Health Care
- Pharmaceutical Sciences
Research Article - (2021) Volume 10, Issue 10
Molecular Characterization of Purified Bacterial Cellulase Enzyme Immobilized in Magnetic Nanoparticle
Poorani Thiruvengadasamy Rajendran1*, Velmanikandan Balasubramanian2, Venupriya Vellingiri3, Ragavi Ravichandran1, Dhivya Dharshini Udhaya Kumar1 and Ponmani Varuna Ramakrishnan42Process Engineer, Divis Laboratories Limited, Hyderabad, India
3Research Scholar, PSG Tech, Coimbatore, Tamilnadu, India
4PG Scholar, SASTRA University, Thanjavore, Tamilnadu, India
Received: 16-Sep-2021 Published: 30-Oct-2021, DOI: 10.35248/2167-7956.21.10.181
Abstract
Background: Plants were rich in lignocellulose and cellulosic content which forms highly complex structure and this needs effective enzymatic catalyzes reaction for useful product development. Various industries like textiles, paper, agriculture and biofuel need enzymatic treatment (cellulase) which costs up to the total cost production of 40% to convert into the useful product.
Methods: To get the better of this economical contingency, the cellulase cost was reduced by immobilizing with Magnetic Nanoparticle (MNP’s). It is hypothesized that cellulose enzyme immobilization with magnetic nanoparticle can meet the economically feasible cellulase production. Present study describes the cellulase molecular characterization isolated from cellulolytic bacteria and its growth parameters were optimized for its enzyme production. The cellulolytic bacteria with efficient substrate hydrolyzing property were chosen and its cellulase activity was evaluated. The cellulase kinetics was calculated using Michaelis - Menten Kinetics (MM kinetics) to find the Vmax and Km.
Results: The purified cellulase was immobilized with magnetic nanoparticle and its efficiency and yield was calculated and characterized with FTIR, SEM and XRD. The peptide mass finger printing of cellulase was evaluated using MALDI-TOF-TOF analysis. The free enzyme and immobilized enzyme was checked for its temperature optimization and stability, pH optimization and stability, substrate specificity, storage stability. The reusability of the immobilized enzyme was also evaluated.
Conclusion: In future, the enzymatically and molecularly characterized cellulase gene from cellulolytic bacteria will be over expressed in E.coli to make the cellulase cost feasible.
Keywords
Cellulase; Enzyme kinetics; Magnetic nanoparticles; Immobilization; Reusability
Introduction
It is documented that plants are the foremost common source of renewable carbon and energy on the world. The plant produce around 4 × 109 tons of cellulose, a structural polysaccharides that is consider as ample biopolymer on the soil containing β-1,4- linked glycosyl residues, along with other polysaccharides [1]. The potential of these biological resources are possible substitutes for diminishing fossil energy resources and becoming increasingly important. The biological degradation of cellulose has been studied for many years, and a number of cellulolytic enzymes, especially cellulases produced by microorganism, play a vital role in many processes of biodegradation of cellulose [2]. These enzymes, which cleave the β-1, 4 bond of cellulose, belong to the large family of glycosyl hydrolases. Cellulase is one of the most useful enzymes in industry. Cellulase can be produced by fungi, bacteria or actinomycetes, but the most common producer is fungi. High cost of cellulase is mainly due to the substrates used in production, and also the slow growth rate of fungi. Bacteria, which has high growth rate as compared to fungi has good potential to be used in cellulase production.
However, the application of bacteria in producing cellulase is not widely used. Bacterial cellulase usually lacks one of the three cellulose activities that are FPase. However, cellulases produced by bacteria are often more effective catalysts. They may also be less inhibited by the presence of material that has already been hydrolyzed (feedback inhibition). The greatest potential importance is the ease with which bacteria can be genetically engineered. This is needed especially in order to enhance cellulose production. Major industrial applications of cellulases are within the textile industry for "biopolishing" of materials like production of the stonewashed look of denims, and in household laundry detergents to enhance fabric softness and brightness. Moreover, they are widely used in food and feed industry to increase nutritional quality and digestibility of animal feed, in treating of fruit juices, in production of biofuel and in brewing industries [3].
In addition, cellulase enzymes are involved in enzymatic hydrolysis of cellulose, one of the most abundant organic materials that can be converted to products with significant commercial interest. [4]. Bioconversion of cellulose to monomeric sugars has been intensively studied as researchers seek to produce bioethanol and bio-based products, food and animal feeds, and many valuable chemicals. For commercial production, microbial enzymes have the enormous advantage of being scalable to high-capacity production by established fermentation techniques. A wide variety of microorganisms are known for their ability to produce cellulase enzymes. One major obstacle facing the development of lignocellulosic biofuels is the cellulose hydrolysis stage. Generally speaking, there is a lack of microorganisms which can produce sufficient amount of all three types of cellulases to efficient breakdown of crystalline cellulose to glucose [5].
Moreover, the bio refining process remains economically unfeasible due to a lack of biocatalysts that can overcome costly hurdles such as cooling from high temperature, pumping of oxygen/stirring, and, neutralization from acidic or basic pH. The extreme environmental resistance of bacteria permits screening and isolation of novel cellulases to help overcome these challenges. Among the group of cellulase enzymes, Carboxy Methyl Cellulase (CMCase) has been used predominantly in the process of ethanol production. The extent of enzyme production by a bacterial culture is a function of fermentation parameters and components of the medium. Optimization of these parameters is a key factor influencing the economic feasibility of enzymatic hydrolysis of biomass prior to fermentation. In this study, the enzyme production of cellulolytic culture was optimized for CMCase (cellulase) production using statistical design of experiments. This cellulolytic bacterium has been isolated by us from processed starch.
The immobilization of enzymes onto nanomaterials such as nanopolymers, nanofiber, and nanoparticles is of high interest because the reduction in the size of the enzyme carrier materials improves the efficiency of immobilized enzymes. Moreover, for surface attachment, smaller particles can provide a larger surface area for the attachment of enzymes, leading to higher enzyme loading per unit mass of particles. However, for industrial biotechnology applications, immobilized enzymes on nanoparticles are limited by problems in recovery, e.g., via centrifugation or filtration. Magnetic Nanoparticles (MNPs) are potentially useful supports for bioactive materials such as peptides, enzymes, antibodies, and nucleic acids, and are easily recovered for reuse. They have low toxicity, and their distinct advantage is their separation from reaction mixtures using magnets. Improved enzyme activity, loading, and stability using enzyme immobilized on MNPs [6] (Figure 1-3).

Figure 1: Mechanism of recycling immobilized cellulose.

Figure 2: Broth culture.
Figure 3: The pure culture.
Materials and Methods
Sample collection
The starch sample from different sources was collected from different sites of Erode district, Tamilnadu, India. The processed starch was used as a source for isolating cellulolytic enzyme producing bacteria. Totally nine samples were collected (Maize starch, Potato starch, LAS-INF, Saumix-IS, Size Magik, Chikmat, AL Texomer, Size Magik-LP4, Saumix-TS).
Inoculation of sample
M17 broth (Himedia) was prepared and sterilized. 5ml broth was poured in 9 clean sterile test tubes and check for its sterility (37ºC for 24 hours). To this broth 10% of the processed starch samples (281 mg) were inoculated. This was incubated at 37°C for 24 hours [7].
Isolation of cellulolytic bacteria
After 24 hours, the broth culture was inoculated in the agar plates containing 1% CMC (Carboxy methyl cellulose) and incubated for 24 hours at 37°C. To identify the cellulose degrading bacteria the plates containing colonies were stained with 1% Congo red solution for 15-20 minutes and de-stained with the NaCl [8]. If the strain was cellulolytic then it started hydrolyzing the carboxy methyl cellulose. The strain was selected as per the colonies with or without clear and transparent zone as cellulase producing (cel+) and cellulase non-producing (cel). After staining, colonies forming zone of clearance was chosen [9].
Identification of cellulolytic bacteria
Morphological characterization of the 24 hour old selected isolate was identified with respect to colour, shape, margin, elevation and configuration. Gram’s staining and endospore test gives the cell characteristics of the isolate. Scanning Electron Microscopy (SEM) and EDAX were done [10,11]. Biochemical characterization like motility test, urease test, indole production test, citrate utilization test were performed following the method of Bergey’s Manual of Systematic Bacteriology. Molecular characterization of the isolate was done using 16SrRNA sequencing from the genomic DNA isolated using Nucleo Spin® Tissue Kit (Macherey-Nagel). The PCR amplification was done in 20 μl reaction volume with the universal primers 16S-RS-F (CAGGCCTAACACATGCAAGTC) and 16S-RS-R (GGGCGGWGTGTACAAGGC). The PCR amplification was carried out with the conditions, for denaturation at 95°C for 5 min, final denaturation at 95°C for 30 sec, annealing at 60°C for 40 sec, initial extension at 72°C for 60 sec, final extension at 72°C for 7 min and hold at 4°C. The amplified gene was confirmed with Agarose gel electrophoresis (1.2%). The PCR product was treated with ExoSAP- IT (USB) and Sequencing reaction was done in a PCR thermal cycler (Gene Amp PCR System 9700, Applied Biosystems) using the Big Dye Terminator v3.1 Cycle sequencing Kit (Applied Biosystems, USA) following manufactures protocol. Finally sequencing analysis was done. The sequence database similarity searches of 16SrRNA gene sequence was done using BLAST tool of NCBI – genebank.
Enzyme assay
The identified isolate was subcultured in the nutrient broth and incubated for 24 hours. This subculture was inoculated in the well containing 1% CMC nutrient agar and incubated for 18, 24, 48, 72 and 96 hours [12]. The incubated plates were stained with Congo red for CMC agar (cellulolytic bacteria) for 15-20 minutes which was further de-stained with NaCl. Halo zone was formed around the colonies in plates and the diameter of the zone of clearance was measured [13].
Enzyme activity
The selected strain was inoculated in CMC containing nutrient broth and incubated for 24 hours. The grown culture was centrifuged at 10,000 rpm for 15 min at 4°C. The supernatant was collected and used as crude enzyme. According to Miller G L reducing sugar test cellulase activity was measured with 1% CMC prepared in PBS (pH 7). 0.5 ml of crude enzyme was mixed with 0.5 ml of substrate (starch or CMC) and incubated for 30 minutes [14]. The reaction was stopped by adding 2 ml of DNS reagent and cooled by adding distilled water 5 ml. This was boiled for 10 minutes at 100°C and measured for its absorbance at 540 nm. The concentration of the reducing sugar was estimated from the glucose standard graph. The unit of enzyme activity was the amount of amylase or cellulase required to catalyze the liberation of reducing sugar equivalent to one mole glucose per minute under the assay condition [15].
Enzyme kinetics
To find the kinetics of cellulase from bacterial sample, different concentration of CMC was taken from the stock solution of 1% CMC respectively prepared using 0.05 M phosphate buffer. The enzyme solution was prepared by taking the supernatant after centrifugation of bacterial sample. To the five different concentration of starch solution and CMC solution, 0.5 ml of enzyme solution was added separately and incubate at different time intervals (5, 15, 30 minutes). The reaction was stopped by adding 2 ml of DNS reagent and boiled in water bath for 10 minutes. Then the absorbance of the samples was measured at 540 nm.
Purification of cellulase enzyme
Ammonium sulphate precipitation: Protein precipitation by salting out technique using ammonium sulphate (NH4(SO4)2) was carried out with constant gentle stirring. This was left overnight and the precipitate was collected by centrifugation at 10,000 × g for 10 min. The precipitate obtained was dissolved in phosphate buffer (50 mM, pH 7.0) and dialyzed against the same buffer with less concentration than before used buffer for 24 h [16].
Ion exchange chromatography: Dialyzed enzyme (2 mL) was loaded onto an anion exchange DEAE Cellulose column. The column was packed with activated DEAE-cellulose equilibrated with 50 mM phosphate buffer (pH 8.0). The height of column was 20 cm with the 2.5 cm diameter. The protein was eluted with the 0.5 to 1 M NaCl gradient. The 10 fractions were collected having 5 mL volume of each fraction with the flow rate of 1mL/min. All the steps were carried out at room temperature.
SDSPAGE: Electrophoresis was performed mainly according to the method described by Laemmli, 1970. To the purified enzyme, equal volume of sample buffer (0.05% bromophenol blue, 5% β- mercaptoethanol, 10% glycerol, and 2% SDS in 0.25M Tris–HCl buffer; pH 6.8) was added and then boiled at 100°C for 2 min. The resulted samples were then subjected to SDSPAGE (resolving gel: 12.5%; stacking gel: 4%). Electrophoresis was performed at room temperature for 1.5hour with 100Volt. The molecular mass (M) of purified cellulase was determined using SDS- PAGE. Phosphorylase B (97 kDa), albumin (66 kDa), ovalbumin (45 kDa), carbonic anhydrase (30 kDa), trypsin inhibitor (20.1 kDa) and α-lactalbumin (14.4 kDa) were used as markers [17].
Zymography: The zymogram was performed to evaluate the activity of enzyme in SDS PAGE. The 12% separating gel of the SDS PAGE was mixed with 0.1% CMC and the gel was run with 100V. After this the gel was washed with 2.5% triton for 1 hour and then the gel was kept in sodium acetate buffer of 4.8pH for 1 hour. Finally the gel was incubated in same buffer for 30 minutes at 50°C. Then the gel was stained with 0.1% congo red stain for 15-20 minutes and then de-stained with 1 M NaCl until a clear band is visible. For further de-staining the gel was put in 5% acetic acid solution.
MALDI – TOF –TOF – MS analysis
The peptide mass fingerprinting of cellulase enzyme from BT5216 strain was analyzed using MALDI-TOF instrument at Indian Institute of Science, Bangalore. Purified cellulase (0.1 mg) was digested with trypsin (12 hr incubation at 37°C). Digested cellulase (0.1 mg) was dissolved in acetonitrile (50% v/v), desalted by zip tip and mixed with equal volume of matrix α- Cyano-4-hydroxycinnamic acid (1 mg/ml in 50% acetonitrile). Cellulase peptide mass finger printing was done by using MALDI TOF-TOF mass spectroscopy. It was performed on an MALDI TOF-TOF analyzer with an Nd- YAG (neodymium-doped yttrium aluminium garnet) laser (355 nm, 200 Hz) operated in accelerated voltage (20 kV). MALDI MS/ MS spectral data was analyzed using Mascot; retrieved amino acid sequences were subjected to the BLASTP and compared with the Protein Data Bank (PDB) [18,19].
Synthesis of magnetic nanoparticles (MNP’S)
Magnetic nanoparticles (Fe3O4) were prepared by co‐precipitating Fe2+ and Fe3+ ions with ammonia solution and treating under hydrothermal conditions as previously reported. A 2:1 molar ratio of ferric and ferrous chlorides was dissolved in water under inert conditions. Chemical precipitation was achieved at 25°C under vigorous stirring by adding 28% NH4OH solution. The precipitates were heated to 80 °C for 30 min, and washed three times with water and once with anhydrous ethanol. The particles were dried for 24 h [20,21].
Immobilization of cellulase enzyme with MNP’S
The immobilization of cellulase on magnetic nanoparticles followed the procedure described. The magnetic nanoparticles were suspended in deionized water at a concentration of 5 mg/ mL. This suspension was sonicated for 1 h, and suspended in 1 mol/L glutaraldehyde solution in deionized water. The support was activated by incubating the magnetic nanoparticles for 1 h at 25°C in a shaker at 250 r/min. The reaction mixture was stored at 4 °C and sonicated at 1 h intervals to ensure uniform dispersion. After 2 h, the mixture was sonicated a final time and heated to 25°C. The cellulose bound nanoparticles were recovered by placing the container on a strong permanent magnet. They were washed twice in water and the resultant supernatants were used for protein analysis. The remaining precipitates were analyzed for enzymatic activity and stability [22].
The immobilization efficiency was calculated by the formula, [23,24]
Immobilization yield % = (Activity of Immobilized enzyme/Activity of free enzyme )* 100
Immobilization Binding Efficiency % = (Total amount of protein binded/Total amount of protein loaded)*100
The immobilized and magnetic nanoparticle was characterized for its interaction, crystalline and particle size by FTIR, XRD and SEM respectively.
1. UV-VIS Spectrophotometer: Perkin Elmer Lambda 35 UVVis spectrometer was used for recording the visible spectra of free cellulase enzyme immobilized magnetic nanoparticles and magnetic nanoparticles.
2. Fourier -Transform Infrared Spectroscopy (FT-IR): The FTIR spectra of the magnetic nanoparticles and immobilized magnetic nanoparticle with cellulase were recorded on Bruker FT-IR in KBr matrix over a spectral width of 4000 to 400 cm-1 at a resolution of 2 cm-1.
3. X- ray Diffraction studies (XRD): X-ray diffraction pattern of the magnetic nanoparticles and immobilized magnetic nanoparticle with cellulase were recorded using the SHIMADZU model XRD 6000 for the diffraction angle ranging 10°-80° at a scan rate of 5°C/min.
4. Scanning Electron Microscopy (SEM): The surface morphology of magnetic nanoparticles and immobilized magnetic nanoparticle with cellulase were studied by recording their SEM micrographs using scanning electron microscopy (JEOL-MODLE 6390) at 30 KV for the magnification range of 2000- 30,000.
Storage stability
The free enzyme and the immobilized enzyme were stored at 4°C and its stability was measured after one day interval for 10 days. The magnetic nanoparticles dissolved in HCL (0.1M) were stored at 4°C and the supernatant was sampled at different intervals to investigate the stability using ultraviolet-visible spectrophotometry. The Optical Density (OD) was detected at 280 nm, at which the OD value was linearly related to the concentrations of cellulase enzyme. Stability was calculated according to
Stability % = (ODs/ODf) * 100
Where ODs was OD value of sample stored for certain time and ODf was OD value of the freshly prepared sample [25].
Reusability
The reusability of the immobilized enzyme was determined by enzyme assay. The immobilized preparation was washed with deionized water followed by enzyme assay buffer. After each cycle of the assay was performed, the immobilized nanoparticles were suspended in buffer and CMC substrate solution. The activity obtained in the first cycle for the immobilized enzyme was taken as the control and represents 100% activity.
Substrate specificity
The free enzyme and the immobilized enzyme was analyzed for its activity with different substrates like CMC, banana fibre, cotton, filter paper, xylan and pectin. The DNS assay was done with these substrates to find the specific substrate for the enzyme.
Temperature and pH optimization
The free enzyme and immobilized enzyme was optimized at different temperature of 50°C to 90°C and pH of 6 to 10. The enzyme activity was done at these temperature and pH separately for both enzymes and optimum temperature and pH was calculated with its high activity at specific temperature and pH [26].
Temperature and pH stability
The free enzyme and immobilized enzyme was stored at different temperature (50°C to 90°C) and different pH (6 to 10) for 30 minutes and the substrate was added to these samples to find its enzyme activity which was incubated at room temperature for 30 minutes. DNS was added to stop the reaction and its activity was found. The best and stable conditions for storing the enzymes were evaluated with this study.
Results
Collection and inoculation of sample
The collected samples listed in Table 1 were inoculated in M17 broth and agar. From the inoculums the isolates UN6871, UN6861, UN8341, UN8431, UN7561, UN7431, UN5371, UN5481, UN5561, UN5691, UN8211, and UN8201 were pure cultured. The selected isolates morphological characteristics were studied and described in Table 2 which was used for further analysis.
| Sample No. | Isolate No. | Sample Source | Quantity of Sample(µg) | Place of Sample Collection | Date of Sample Collected |
|---|---|---|---|---|---|
| LAS 001 | UN8561 | LAS – INF | 281 (10% of 5ml broth) | Erode | 17.11.2015 |
| LAS 002 | UN8651 | ||||
| SMK 001 | UN6871 | Size Magik | |||
| SMK 002 | UN6861 | ||||
| CKT 001 | UN8341 | Chikmat | Coimbatore | 18.11.2015 | |
| CKT 002 | UN8431 | ||||
| ALT 001 | UN7561 | AL Texomer | |||
| ALT 002 | UN7431 | ||||
| SLP 001 | UN5371 | Size Magik – LP4 | Salem | 1 9.11.2015 |
Table 1: Sample details.
| Isolate No. | Media Used | Colon Morphology |
|---|---|---|
| UN8561 | M17 Broth and agar | Thin round shaped colonies appeared |
| UN8651 | Thin, flat and small round shaped colonies | |
| UN6871 | Small flat colonies formed | |
| UN6861 | Small flat colonies formed | |
| UN8341 | White mass of round colonies formed with rigid outer surface | |
| UN8431 | White thick mass of round colonies formed | |
| UN7561 | Dirty white flat, small colonies formed | |
| UN7431 | Dirty white flat, small colonies formed | |
| UN5371 | White thick mass of large round colonies formed | |
| UN5481 | White thick mass of large round colonies formed | |
| UN5561 | White thick mass of large round colonies formed | |
| UN5691 | White thick mass of large round colonies formed | |
| UN8211 | Small, flat round shaped colonies formed | |
| UN8201 | No colonies formed |
Table 2: Morphological characteristics of isolates.
Isolation of hydrolytic bacteria
The bacteria isolated from processed flour were inoculated in CMC medium. From the 11 isolates only one strain showed high level of cellulase production. The CMC nutrient agar plates forming colonies stained with congo red was observed and the strain shown in Figure 4 was chosen for further study. The isolated bacterial strain has the ability to hydrolyze the substrate, carboxyl methyl cellulose which can be confirmed with the zone of clearance, rich in cellulase enzyme production [27].

Figure 4: Strain UN8211 with cellulase activity.
Identification of hydrolytic bacteria
1. Morphological characteristics: The isolated and selected strain UN8211 for cellulase production was identified morphologically by SEM and EDAX. The SEM micrograph gives the clear view that the isolated bacteria were rod shaped showed in Figure 5 based on its structure morphology. The EDAX was performed to verify the elemental composition of the isolated bacteria which was found to be rich in oxygen, carbon, calcium, phosphate and in this spectrum process the peaks omitted 1.041, 1.251, 9.686 keV. The spectrum graph was shown in Figure 6.

Figure 5: SEM micrograph of UN8211 isolate.

Figure 6: EDAX spectrum of UN8211 isolate.
2. Biochemical characteristics: The cell characteristics and biochemical characteristics of the isolated strain UN8211 were found to be Gram positive, motile and endospore forming and negative with urease production, indole production and citrate utilization. Table 3 depicts the cell characteristics of isolate UN8211 (Figure 7-10).
| S No. | Assays | Result |
|---|---|---|
| 1 | Gram staining | Positive |
| 2 | Endospore test | Positive |
| 3 | Motility | Positive |
| 4 | Urease test | Negative |
| 5 | Indole production test | Negative |
| 6 | Citrate utilization | Negative |
| 7 | Morphology | Rod shaped |
Table 3: Biochemical characteristics of UN8211 isolate.

Figure 7: Gram staining.

Figure 8: Endospore staining.

Figure 9: Genomic DNA isolation.

Figure 10: PCR for 16S rRNA Lane 1, 2 – amplified isolates, Lane 3 – marker (DNA ladder).
3. Genomic identification: The PCR product of the 16SrRNA sequencing was analyzed using agarose gel electrophoresis and the sequence was submitted in the NCBI – gene bank with accession number KX247285. From the database similarity searches with BLAST the genus was found to be bacillus and the sequence was 100% identity with Bacillus thuringiensis pak2310. Further by using neighborhood joining method the phylogenetic tree was build which depicts the closest isolates in similarity to the tested strain. Neighbor-joining tree showing the phylogenetic position of Bacillus thuringiensis BT5216 and related species based on partial 16S rRNA gene sequences. The scale bar indicates a 0.02 substitution per nucleotide position (Figure 11).

Figure 11: Phylogenetic tree for isolate UN8211.
Enzyme assay
The CMC agar plates after incubation for 24 hours showed a halo formation around the colonies. This zone of clearance was measured and its average distance was found to be 300 mm in diameter. Zone forms due to the catalase reaction of the enzyme (cellulase) with CMC as substrate which was stained by Congo red shown in Figure 12.

Figure 12: Cellulase assay.
Enzyme activity
The enzyme activity is the amount of cellulase, release reducing sugars at the rate of 1μmol/min under the conditions of the assay. The reducing sugars from the samples were measured using DNS reagent. The absorbance was measured the enzyme activity was found for the enzyme and its concentration was reviewed from the standard curve of glucose shown in Figure 13. From this using the formula,
Enzyme activity = μg of glucose released X Total assay volume X Dilution factor/ Volume of enzyme used X Volume in cuvette X Incubation time

Figure 13: Glucose standard graph.
From the standard graph the concentration of the cellulase was found to be 1.0060 mg/ml and its enzyme activity was found to be 0.4757mg/ml/min [28].
Enzyme kinetics
The initial reaction rate of cellulase was determined with CMC concentration ranging from 0.5mg/ml to 2.5mg/ml in the graph shown in Figure 14 and after incubating at 37°C for different time intervals (5, 10, 15minutes). Then enzyme activity per unit time was determined in each substrate concentration. The final enzyme rate was calculated from the graph shown in Figure 15. From the value of S (substrate concentration) and V (enzyme rate) the Lineweaverburk plot was plotted. This graph gives the Y intercept (1/Vmax) and X intercept (- 1/Km) from which Vmax and Km value was calculated. This was found to be 1.61689 M and 1.9585 X 10-6 (mg/min/ml) for cellulose (Figure 16).

Figure 14: Standard graph for CM.

Figure 15: Rate of enzyme at different concentration.

Figure 16: Line Weaver Burk plot for Km and Vmax determination.
Purification of cellulase enzyme
The bacterial crude homogenate was purified to study its efficiency and yield percentage. The cellulase enzyme was purified with ammonium sulphate precipitation, dialysis and DEAE Ion exchange chromatography. Ammonium sulphate precipitation was done with 30- 50% of salt and it saturated at these ratios. Further the salt contamination was removed by Dialysis and DEAE ion exchange was run with different NaCl concentrations. The elution profile of cellulase enzyme in DEAE ion exchange chromatography was shown in Figure 18 [29]. From this it was found that the fractions with NaCl concentration of 0.2, 0.3, 0.6 and 0.8 M has high enzyme activity and these were taken for further analysis. Also the plate assay for each purification step was shown in Figure 17. The purification table was made with specific activity, purification fold and efficiency for each purification step and was shown in Table 4. The specific activity at final purification was found to be 6876.47 Units/mg and it was 476.87 fold purified. After purification the yield percentage of cellulase was found to be 18.23% and its efficiency was increased to 86.93 (Figure 19).
| Purification Steps | Total Protein (mg) | Total Activity (Units) | Specific Activity (Units/mg) | Purification (Fold) | Yield (%) | Efficiency |
|---|---|---|---|---|---|---|
| Crude Homogenate | 177.74 | 2564 | 14.42 | 1 | 100 | 1 |
| Ammonium sulphate precipitation | 18.272 | 2395.2 | 131.085 | 9.09 | 93.4 | 8.49 |
| Dialysis | 1.552 | 2149.6 | 1385.05 | 96.05 | 83.83 | 80.51 |
| DEAE-ion exchange chromatography | 0.068 | 467.6 | 6876.47 | 476.87 | 18.23 | 86.93 |
Table 4: Purification table.

Figure 17: Enzyme activity – plate assay of 1) Ion exchange sample, 2) Ammonium sulphate precipitation sample, 3) Dialysis sample, 4) Crude homogenate and 5) Standard cellulose.

Figure 18: DEAE-Ion exchange elution profile.

Figure 19: SDS gel with lanes, L1 – Standard cellulase, L2 – Crude enzyme, L3 – Ammonium sulphate precipitation, L4 – Dialysis, L5 and L6 – Ion exchange chromatography.
Zymography
The purified cellulase enzyme was ascertained for its activity by zymogram. From this a clear zone of inhibiting the substrate CMC by cellulase was observed. This clear zone was formed at the same molecular weight shown before in SDS PAGE. So the formed zone was corresponding to the activity of the purified enzyme. The clear zone was shown in the Figure 20.

Figure 20: Zymography gel with lanes, L1 – Standard cellulase, L2 – Crude enzyme, L3 Ammonium sulphate precipitation, L4 and L5 – Dialysis, L6 and L7 – Ion exchange chromatography.
MALDI –TOF-TOF-MS analysis
The peptide mass finger printing was evaluated with the MALDI TOF-TOF analysis which gives the mass to charge ratio of peptide corresponding to the cellulase enzyme purified from SDS PAGE. The graph in Figure 21 predicts the peptide peaks having different mass. These peak values were compared and analyzed in the Mascot search and from this the amino acid sequence of the protein has 100% coverage with the SDF08511.1 hypothetical protein SAMN04487781_0194 [Cellulosimicrobium cellulans], AAT48369.1 cellulose synthase catalytic subunit [Mesotaenium caldariorum], SCC17161.1 Protein of unknown function [Bacillus thuringiensis]. These proteins were analyzed with the BLAST P in PDB to know the similar protein [30]. From the PDB results Clustal W omega was build shown in Figure 22 to read the matched conserved regions. This gives the close relation of the isolated protein to cellulase.

Figure 21: Peptide mass finger printing showing peaks at specific mass.

Figure 22: Clustal W showing conserved regions with peaks showing 100% coverage proteins and endoglucanase protein.
Synthesis of magnetic nanoparticle
The synthesized magnetic nanoparticle (MNP’s) was precipitated as black powder and has its magnetic properties. The MNP’s mixed in solution on contact with magnet got attracted towards it shows that the synthesized MNP’s has magnetic properties. The attraction between magnet and MNP’s in solution was represented in Figure 23.

Figure 23: Magnetic nanoparticle and its attraction.
Immobilization of MNP’s with cellulase enzyme
The synthesized MNP’s was immobilized with cellulase enzyme to maintain enzymes stability and reusability. The immobilized cellulase yield % was calculated and found to be 87.37% and the binding efficiency of the immobilized enzyme was found to be 62.5%. Further the immobilization was characterized with UVVis spectrophotometer, interaction studies were done with FTIR, stability studies were done with XRD and SEM [31].
1. UV-VIS spectrophotometer: From the UV-VIS spectra it was found that the cellulase enzyme isolated from BT5216 strain has it peak at 260 nm- 280 nm and it was shown in Figure 24A the magnetic nanoparticle and immobilized magnetic nanoparticles were initially analyzed for its UV absorbance and from the graph it was found that the immobilized MNP’s has lesser absorbance than magnetic nanoparticles and both the curves has its peak at 243 nm and 339n m which suggests the absorbance of magnetic nanoparticle. The peaks were shown in the Figure 24B.

Figure 24: A) Free cellulase enzyme showing peak at 280 nm and B) immobilized magnetic nanoparticle and magnetic nanoparticle showing peaks at 339.2 nm.
2. Fourier -Transform Infrared Spectroscopy (FT-IR): The interaction between the cellulase enzyme and the MNP’s were studied through FTIR spectra.
The FTIR spectrum shows a clear view of interactions between the molecules. The peaks at 1690cm-1 – 1524 cm-1 were specific for protein molecules. The band for NH2 of cellulase was observed at 1633.5 cm-1. The NH2 stretch also extends at 3401.15 cm-1 for cellulase group. The stretching pattern near 1524.93 cm-1 shows the carboxyl group of the cellulase. Whereas the other bands between 993.85 cm-1 to 772.79 cm-1 were slightly less intensified bands. The band at 2885.36 cm-1 shows the C-H stretch (Figures 25 and 26) [32].

Figure 25: FTIR spectra of magnetic nanoparticle.

Figure 26: FTIR spectra of Immobilized magnetic nanoparticle.
3. X-Ray Diffraction studies (XRD): The stability and crystalline nature of magnetic and immobilized nanoparticle was studied through X-Ray diffraction studies. From the Figure 27 the XRD pattern of both the free enzyme and immobilized enzyme illustrates that the magnetic nanoparticle displayed crystalline peaks at 2θ values 35.39º, 29.91º and 21.4º 45º. The diffraction peak at 35.39º is very sharp indicating that the magnetic nanoparticle is crystalline in nature. The crystalline peaks for immobilized magnetic nanoparticles observed were 35.5º, 31.2º and 30.2º. The peaks were comparatively sharper than that observed for magnetic nanoparticle indicating that the enhancement of crystallinity in the magnetic nanoparticle. The above observation of nearly identical diffraction features of magnetic nanoparticle and immobilized magnetic nanoparticle with cellulase implied that the loading of the enzyme in magnetic nanoparticle does not affect the crystallinity.

Figure 27: XRD plot for Theta vs. Intensity.
4. Scanning Electron Microscopy (SEM): The magnetic nanoparticles and cellulase immobilized magnetic nanoparticles were analyzed and characterized for its particle size analysis using SEM which from Figure 28 illustrates the nano sized spherical particles formed. From the picture it was found that the immobilized sample was regular and less agglomerate than magnetic nanoparticle which gives the interaction between the cellulase and nanoparticle. This interaction minimizes the agglomeration due to the amide bond in cellulose enzyme.

Figure 28: A) SEM micrograph of magnetic nanoparticle and B) SEM micrograph of immobilized magnetic nanoparticle.
Storage stability
The free enzyme and immobilized enzyme was evaluated for its storage stability which was shown in the Figures 29-32. It was found that the free enzyme has high enzyme stability at the first 4 days and its stability decreases slowly. Within 10 days the enzyme stability becomes very less [33]. The immobilized enzyme retains its stability over 10 days and it has only minimum reduction in stability after long storage. Hence the immobilized enzyme with the magnetic nanoparticles has high stability when compared to free enzyme.

Figure 29: Bar graph of storage stability of free cellulase and immobilized.

Figure 30: Comparison graph of storage stability of free cellulase and at 4°C.

Figure 31: Bar graph of substrate specificity for free cellulase and immobilized cellulose.

Figure 32: Comparison graph of substrate specificity for free cellulase and immobilized cellulose.
Substrate specificity
The purified cellulase enzyme was analyzed for its substrate specificity to evaluate its subclass of enzyme. The different substrates like filter paper, cotton, banana fibre, xylan, pectin and CMC was used to analyze the enzymes efficiency against specific substrate. The DNS assay was done for each substrate and it was found that the CMC and banana fibre shows high activity than other substrates. Hence this cellulase enzyme was found to be Endo- gluconase.
Reusability
The main feature of the immobilized cellulase in magnetic nanoparticle was to reuse the enzyme for several times. The Figure 33 shows the reusability of the immobilized enzyme for 8 times. The enzyme activity was retained even after 8 times of hydrolysis with CMC substrate. From the Figure 34 it was noted that the residual activity of enzyme was 100% on first day and reduced to about 53% on ninth day.

Figure 33: Plot for reusability of immobilized cellulase enzyme.

Figure 34: 3D plot for reusability of immobilized cellulase enzyme with Residual activity and Enzyme activity.
Temperature optimization
The free enzyme and immobilized enzyme was optimized for different temperatures with its activity. From the Figure 35 it was noted that the both free and immobilized enzyme has high activity at 60°C and immobilized enzyme has slightly higher activity than free enzyme at all temperature [34].

Figure 35: Temperature optimization plot for free cellulase and immobilized cellulose.
Temperature stability
The Figure 36 shows that the free enzyme and immobilized enzyme has good stability at different temperatures [35]. The free enzyme has efficient enzyme activity at 70°C and 80°C. There is a steep fall at 90°C where the enzyme activity after incubation at 90°C is very low and shows less stability at higher temperatures and the immobilized enzyme was stable at higher temperatures when compared to free enzyme.

Figure 36: Temperature stability plot for free cellulase and immobilized cellulose.
pH optimization
The free enzyme and immobilized enzyme was evaluated for its activity at different pH. From the Figure 37 it was calculated that the both free enzyme and immobilized enzyme has high enzyme activity at pH 7 and the enzyme activity falls down at other pH for both free enzyme and immobilized enzyme.

Figure 37: pH optimization plot for free cellulase and immobilized cellulose.
pH stability
Storage stability at different pH was analyzed for free cellulase enzyme and immobilized cellulase enzyme. From the Figure 38 it was found that the free enzyme was stable at pH 7, 9 and 10 and shows good activity at these pH [36]. Immobilized enzyme has high stability in pH 6, 8 and 9. From this it was clear that the immobilized enzyme has high stability in different pH than free enzyme.

Figure 38: pH stability plot for free cellulase and immobilized cellulose.
Discussion
A native bacterium was successfully isolated from the processed starch and screened for cellulase production. The isolate was identified as Bacillus thuringiensis BT5216 submitted in the gene bank with the accession number KX247285. From the enzyme characterization the cellulase activity was found to be 0.4757 mg/ ml/min. The enzyme kinetics was evaluated and it’s Vmax and Km value was calculated as 1.61689 M and 1.9585 X 10-6 (mg/min/ ml) respectively for cellulase from Lineweaver-burk plot. The cellulase enzyme was purified and its purification fold was found to be 476.87. The specific activity at final purification was found to be 6876.47 Units/mg. After purification the yield percentage of cellulase was found to be 18.23% and its efficiency was increased to 86.93. The molecular weight of the purified enzyme was found to be 34 KDa. The Zymography studies were found to give enzyme activity at the same molecular weight in the SDS PAGE. The MALDI-TOF-TOF analysis of the cellulase enzyme gives the 100% sequence similarity coverage with SDF08511.1 hypothetical protein SAMN04487781_0194 [Cellulosimicrobium cellulans], AAT48369.1 cellulose synthase catalytic subunit [Mesotaenium caldariorum], SCC17161.1 Protein of unknown function [Bacillus thuringiensis] and forms 0.447% identity with Crustal W analysis. The magnetic nanoparticles were synthesized and were immobilized with cellulase enzyme and its yield % was calculated and found to be 87.37% and the binding efficiency of the immobilized enzyme was found to be 62.5% the immobilized nanoparticles were characterized for its interaction, crystallinity and particle size analysis with FTIR, XRD and SEM. The free enzyme and immobilized enzyme has best activity at 60°C and pH 7. The free enzyme and the immobilized enzyme were stable at 60°C and 80°C respectively. Free enzyme and immobilized enzyme has stability with high enzyme activity at pH 7 and pH 6 respectively. The enzyme stored at 4°C is more stable for 4 days and has steep reduction in its residual activity within 10 days. Where the immobilized enzyme stored at same temperature was stable for 10 days with very less reduction in its activity. The substrate specificity was found to be very specific for CMC and banana fibre substrates. Finally the reusability of the immobilized enzyme was calculated and the enzyme activity was found to be retained even after 8 times of hydrolysis with CMC substrate and its residual activity was 100% on first day and reduced to about 53% on ninth day.
REFERENCES
- Bagewadi ZK, Bhavikatti JS, Muddapur UM, Yaraguppi DA, Mulla SI. Statistical optimization and characterization of bacterial cellulose produced by isolated thermophilic Bacillus licheniformis strain ZBT2. Carbohydr Res. 2020;49:107979.
- Nisar K, Abdullah R, Kaleem A, Iqtedar M. Statistical optimization of cellulase production by Thermomycesdupontii. Iran J Sci Technol Trans. A: Sci. 2020;44(5):1269-1277.
- Singh R, Kumar M, Mittal A, Mehta PK. Microbial cellulases in industrial applications. Annals of Applied Bio-Sciences. 2016;3(4):23-29.
- Piriya PS, Vasan PT, Padma VS, Vidhyadevi U, Archana K, Vennison SJ. Cellulosic ethanol production by recombinant cellulolytic bacteria harbouringpdc and adh II genes of Zymomonasmobilis. Biotechnol Res Int. 2012;2012.
- Khokhar I, Haider MS, Mushtaq S, Mukhtar I. Isolation and screening of highly cellulolytic filamentous fungi. J Appl Sci Environ Manage. 2012;16.
- Selvam K, Govarthanan M, Senbagam D, Kamala-Kannan S, Senthilkumar B, Selvankumar T. Activity and stability of bacterial cellulase immobilized on magnetic nanoparticles. Chinese J Catal. 2016;37(11):1891-1898.
- Huang S, Sheng P, Zhang H. Isolation and identification of cellulolytic bacteria from the gut of Holotrichiaparallelalarvae (Coleoptera: Scarabaeidae). Int J Mol Sci. 2012;13(3):2563-2577.
- Ariffin H, Abdullah N, UmiKalsom MS, Shirai Y, Hassan MA. Production and characterization of cellulase by Bacillus pumilus EB3. Int J Eng Technol. 2006;3(1):47-53.
- Patagundi BI, Shivasharan CT, Kaliwal BB. Isolation and characterization of cellulase producing bacteria from soil. Int J Curr Microbiol App Sci. 2014;3(5):59-69.
- Rawway M, Ali SG, Badawy AS. Isolation and identification of cellulose degrading bacteria from different sources at Assiut Governorate (Upper Egypt). J Ecol Heal Environ. 2018;6:15-24.
- Beeson WT, Vu VV, Span EA, Phillips CM, Marletta MA. Cellulose degradation by polysaccharide monooxygenases. Annu Rev Biochem. 2015;84:923-946.
- Peterson S. Cellulose degradation by three strains of bacteria found in the gut of Zootermopsis angusticollis. (Master's thesis, The Evergreen State College). 1995.
- Zhao C, Lu X, Deng Y, Huang Y, Liu B. Purification and characterization of thermostable cellulase from consortium XM70 in terrestrial hot spring with sugarcane bagasse. Trop J Pharm Res. 2015;14(4):591-598.
- Yassien MA, Jiman-Fatani AA, Asfour HZ. Production, purification and characterization of cellulase from Streptomyces sp. Afr J Microbiol Res. 2014;8(4):348-354.
- Yin LJ, Lin HH, Xiao ZR. Purification and characterization of a cellulase from Bacillus subtilis YJ1. J Mar Sci Technol. 2010;18(3):466-471.
- Jagannathan V, Singh K, Damodaran M. Carbohydrate metabolism in citric acid fermentation.4. Purification and properties of aldolase from Aspergillusniger. Biochem J. 1956;63(1):94.
- Tork S.E., Aly M.M., Elsemin O. A new l-glutaminase from Streptomyces pratensis NRC 10: Gene identification, enzyme purification, and characterization. Int J Biol Macromol. 2018;113:550-557.
- Chaturvedi AK, Mishra A, Tiwari V, Jha B. Cloning and transcript analysis of type 2 metallothionein gene (SbMT-2) from extreme halophyte Salicornia brachiata and its heterologous expression in E. coli. Gene. 2012;499(2):280-287.
- Mishra A, Joshi M, Jha B. Oligosaccharide mass profiling of nutritionally important Salicornia brachiata, an extreme halophyte. Carbohydr Polym. 2013;92(2):1942-1945.
- Koneracka MA, Kopcansky P, Antalık M, Timko M, Ramchand CN, Lobo D, et al. Immobilization of proteins and enzymes to fine magnetic particles. J Magn Magn Mater. 1999;201(1-3):427-430.
- Mehta RV, Upadhyay RV, Charles SW, Ramchand CN. Direct binding of protein to magnetic particles. Biotechnol. Tech. 1997;11(7):493-496.
- Abbaszadeh M, Hejazi P. Metal affinity immobilization of cellulase on Fe3O4 nanoparticles with copper as ligand for biocatalytic applications. Food Chem. 2019;290:47-55.
- Buntic AV, Pavlovic MD, Antonovic DG, Siler-Marinkovic SS, Dimitrijevic-Brankovic SI. Utilization of spent coffee grounds for isolation and stabilization of Paenibacillus chitinolyticus CKS1 cellulase by immobilization. Heliyon. 2016;2(8):e00146.
- Abraham RE, Verma ML, Barrow CJ, Puri M. Suitability of magnetic nanoparticle immobilized cellulases in enhancing enzymatic saccharification of pretreated hemp biomass. Biotechnol Biofuels. 2014;7:90.
- Salvador M, Moyano A, Martínez-García JC, Blanco-López MC, Rivas M. Synthesis of superparamagnetic iron oxide nanoparticles: SWOT analysis towards their conjugation to biomolecules for molecular recognition applications. J Nanosci Nanotechnol. 2019;19(8):4839-4856.
- Aarthi C, Khusro A, Agastian P. Carboxymethyl cellulase production optimization from Glutamicibacterarilaitensisstrain ALA4 and its application in lignocellulosic waste biomass saccharification. Prep Biochem Biotechnol. 2018;48.(9):853-866.
- Chamoli S, Yadav E, Saini JK, Verma AK, Navani NK, Kumar P. Magnetically recyclable catalytic nanoparticles grafted with Bacillus subtilis β-glucosidase for efficient cellobiose hydrolysis. Int J Biol Macromol. 2020;164:1729-1736.
- Dal Magro L, Silveira VC, de Menezes EW, Benvenutti EV, Nicolodi S, Hertz PF, et al. Magnetic biocatalysts of pectinase and cellulase: Synthesis and characterization of two preparations for application in grape juice clarification. Int J Biol Macromol. 2018;115:35-44.
- Dave BR, Parmar P, Sudhir A, Panchal K, Subramanian RB. Optimization of process parameters for cellulase production by Bacillus licheniformis MTCC 429 using RSM and molecular characterization of cellulase gene. J Bioproces Biotech. 2015;5:3.
- Du R, Song Q, Zhang Q, Zhao F, Kim RC, Zhou Z, et al. Purification and characterization of novel thermostable and Ca-independent α-amylase produced by Bacillus amyloliquefaciens BH072. Int J Biol Macromol. 2018;115:1151-1156.
- Ega SL, Drendel G, Petrovski S, Egidi E, Franks AE, Muddada S. Comparative analysis of structural variations due to genome shuffling of Bacillus Subtilis VS15 for improved cellulase production. Int J Mol Sci. 2020;21(4):1299.
- Kim H, Lee SJ, Shin KS. Characterization of new oligosaccharide converted from cellobiose by novel strain of Bacillus subtilis. Food Sci Biotechnol. 2018;27(1):37-45.
- Lakshmi ES, Rao MN, Sudhamani M. Response surface methodology-artificial neural network based optimization and strain improvement of cellulase production by Streptomyces sp. Biosci j. 2020;36:4.
- Liu Z, Li J, Jie C, Wu B, Hao N. A multifunctional α-amylase BSGH13 from Bacillus subtilis BS-5 possessing endoglucanase and xylanase activities. Int J Biol Macromol. 2021;171:166-176.
- Marques GL, dos Santos Reis N, Silva TP, Ferreira ML, Aguiar-Oliveira E, de Oliveira JR, et al. Production and characterization of xylanase and endoglucanases produced by Penicillium roquefortiATCC 10110 through the solid-state fermentation of rice husk residue. Waste biomass valor. 2018;9(11):2061-2069.
- Zang X, Liu M, Fan Y, Xu J, Xu X, Li H. The structural and functional contributions of β-glucosidase-producing microbial communities to cellulose degradation in composting. Biotechnol Biofuels. 2018;11(1):1-3.
Citation: Rajendran PT, Balasubramanian V, Ravichandran R, Vellingiri V, Kumar DDU, Ramakrishnan PV (2021) Molecular Characterization of Purified Bacterial Cellulase Enzyme Immobilized in Magnetic Nanoparticle. J Biol Res Ther 10:181.
Copyright: © 2021 Rajendran PT, et al. This is an open-access article distributed under the terms of the Creative Commons Attribution License, which permits unrestricted use, distribution, and reproduction in any medium, provided the original author and source are credited.

